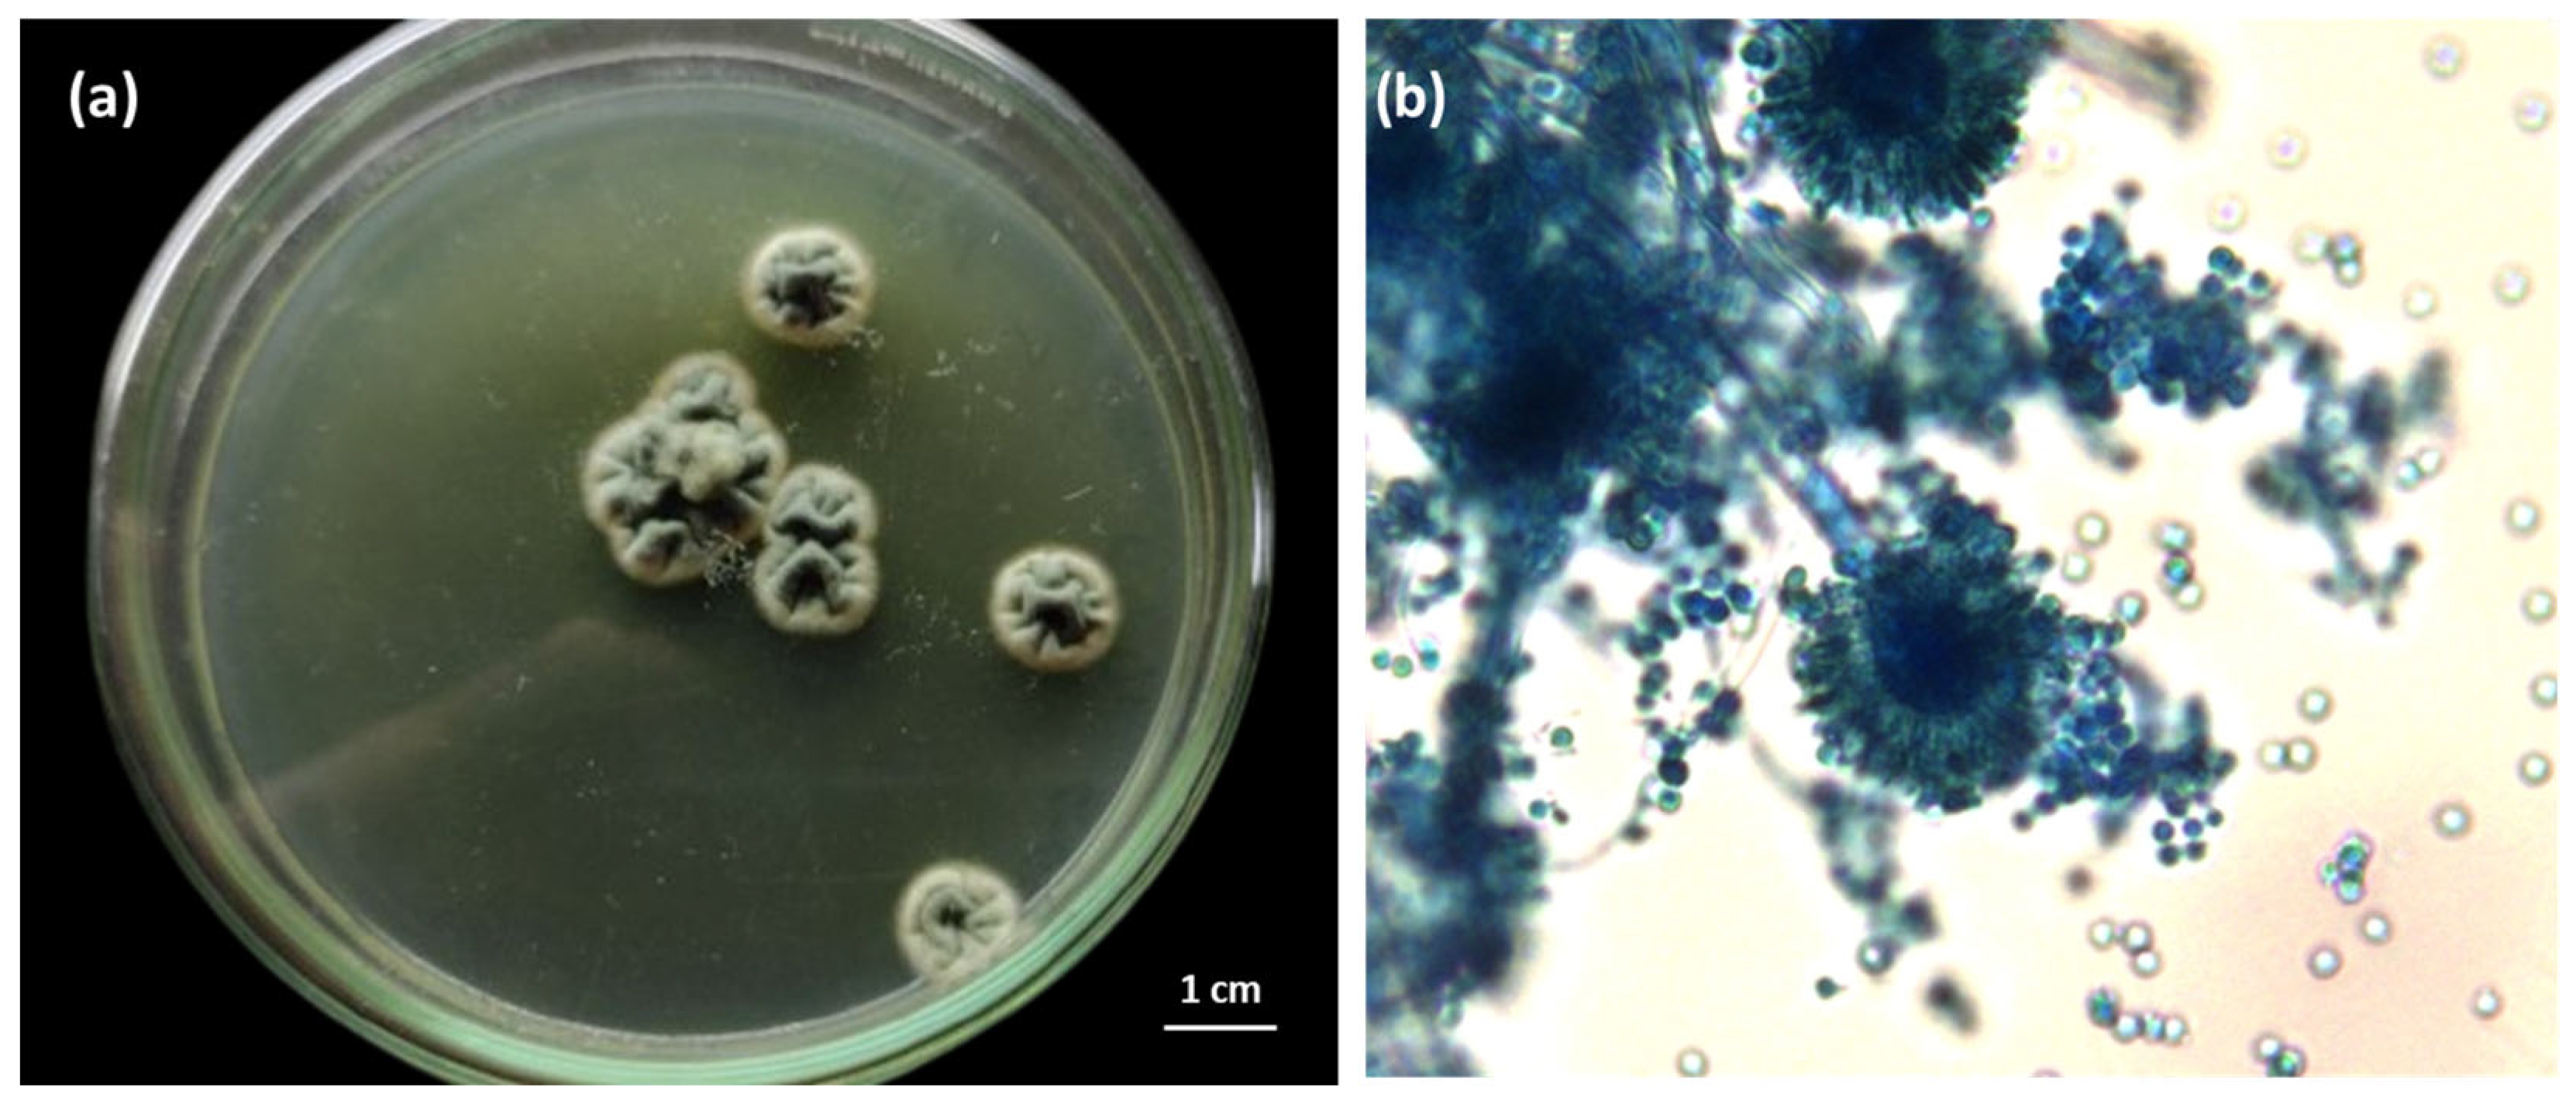
Applmicrobiol 05 00071 g003
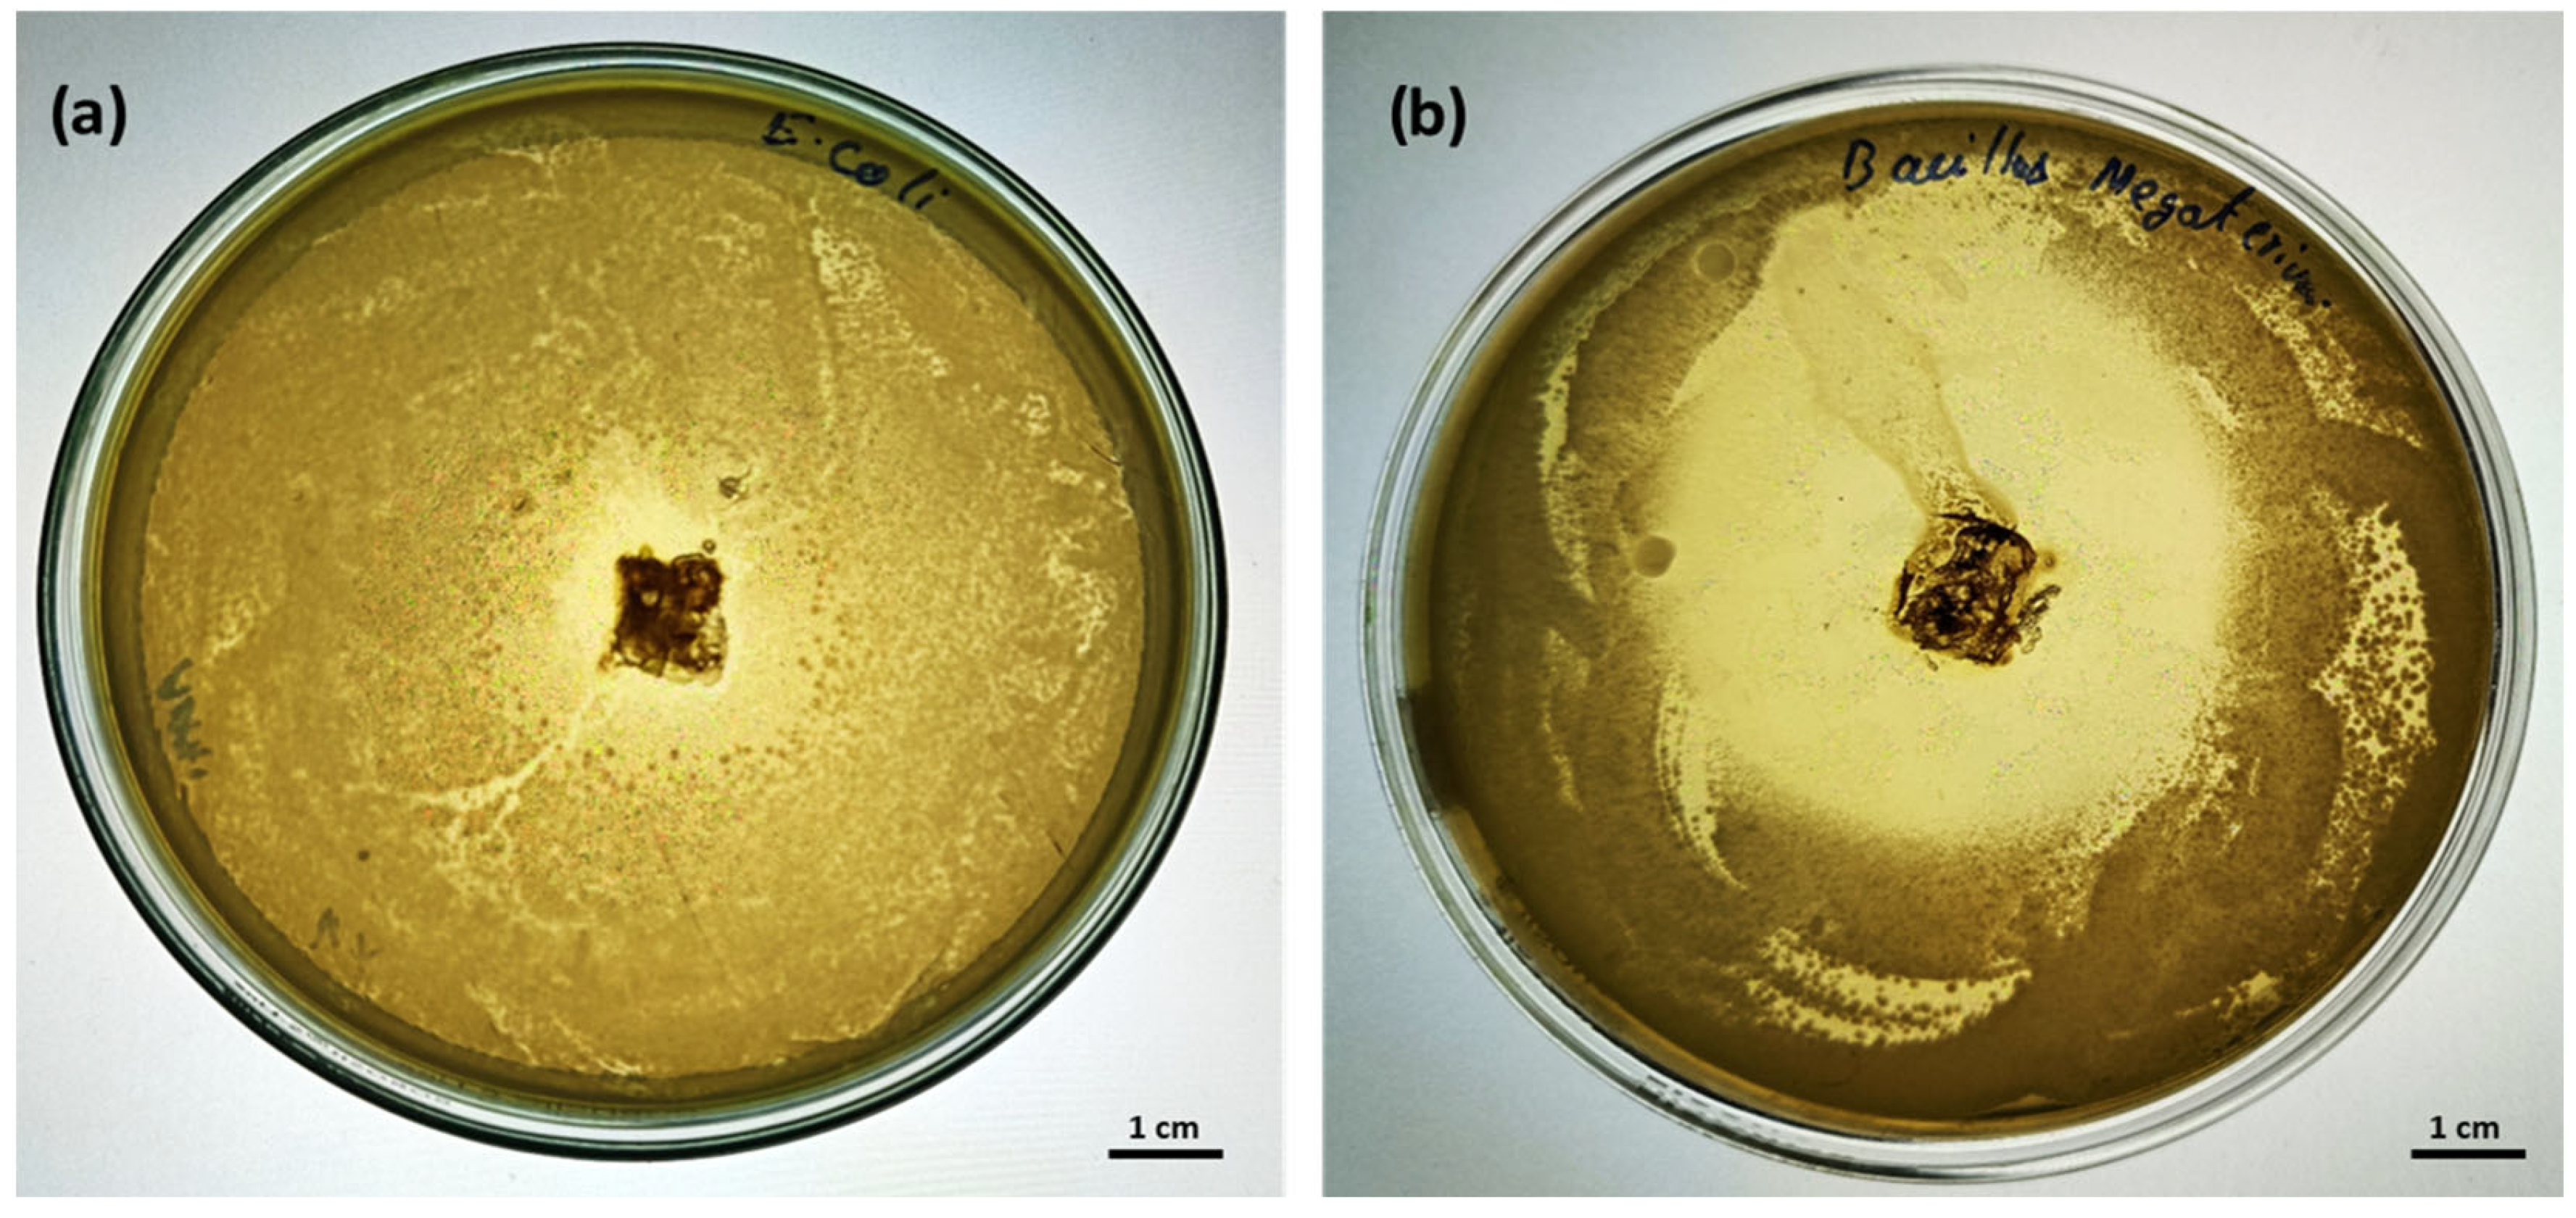
Applmicrobiol 05 00071 g013

Harnessing Wild Jackfruit Extract for Chitosan Production by Aspergillus versicolor AD07: Application in Antibacterial Biodegradable Sheets
Abstract
1. Introduction
2. Materials and Methods
2.1. Isolation of Fungal Strain for Chitosan Production
2.2. Biochemical and Molecular Characterization
2.3. Production of Fungal Biomass
- (i)
- JE + P: Wild jackfruit extract (100 mL) + peptone (10 g/L)
- (ii)
- JE + D: Wild jackfruit extract (100 mL) + dextrose (40 g/L)
- (iii)
- JE + P + D: Wild jackfruit extract (100 mL) + dextrose (40 g/L) + peptone (10 g/L)
- (iv)
- JE: Wild jackfruit extract (100 mL)
2.4. Extraction of Chitosan from the Cultivated Fungal Biomass
2.5. Characterization of Extracted Fungal Chitosan
2.6. Synthesis of Chitosan Sheet Incorporating Lemongrass Oil
Antimicrobial Activity of the Chitosan Sheet
2.7. Biodegradation Studies Using the Fabricated Chitosan Sheet
2.8. Shelf Life Extension Study Coating the Paneer with Chitosan Sheet
3. Results and Discussions
3.1. Isolation of Fungal Strain for Chitosan Production
3.2. Biochemical and Molecular Characterization
3.3. Extraction of Chitosan from the Cultivated Fungal Biomass
3.4. Characterization of Extracted Fungal Chitosan
3.5. Synthesis of Chitosan Sheet Incorporating Lemongrass Oil
Antimicrobial Activity of the Chitosan Sheet
3.6. Biodegradation Studies Using the Fabricated Chitosan Sheet
3.7. Shelf Life Extension Study Coating the Paneer with Chitosan Sheet
4. Conclusions
Author Contributions
Funding
Data Availability Statement
Acknowledgments
Conflicts of Interest
Abbreviations
| SDA | Sabouraud dextrose agar |
| SDB | Sabouraud dextrose broth |
| JE | Wild jackfruit extract |
| P | Peptone |
| D | Dextrose |
| FTIR | Fourier transform infrared spectroscopy |
| XRD | X-ray diffraction |
| TGA | Thermogravimetric analysis |
| DTA | Differential thermal analysis |
| DSC | Differential scanning calorimetry |
References
- Abubakar, I.R.; Maniruzzaman, K.M.; Dano, U.L.; AlShihri, F.S.; AlShammari, M.S.; Ahmed, S.M.S.; Al-Gehlani, W.A.G.; Alrawaf, T.I. Environmental Sustainability Impacts of Solid Waste Management Practices in the Global South. Int. J. Environ. Res. Public Health 2022, 19, 12717. [Google Scholar] [CrossRef] [PubMed]
- Sreehari, S.; Mridul, U.; Anish, N.; Nilina, J.; Adhithya Sankar, S.; Liya Merin, S. Bioprospecting of Fish Scale Waste as a Cost Effective Substrate for Crude Protease Production Using Stenotrophomonas Koreensis SH32 and Its Multifunctional Applications: A Sustainable Strategy for Circular Bioeconomy. Biomass Bioenergy 2025, 197, 107811. [Google Scholar] [CrossRef]
- Peter, D.; Rathinam, J.; Vasudevan, R.T. Bioconversion of Waste to Wealth as Circular Bioeconomy Approach. In Biotechnology for Zero Waste; WILEY-VCH GmbH: Weinheim, Germany, 2022; pp. 409–420. [Google Scholar]
- Phiri, R.; Mavinkere Rangappa, S.; Siengchin, S. Agro-Waste for Renewable and Sustainable Green Production: A Review. J. Clean. Prod. 2024, 434, 139989. [Google Scholar] [CrossRef]
- Nakintu, J.; Albrecht, C.; Olet, E.A.; Andama, M.; Lejju, J.B. Genealogy and Cultural Heritage of Jackfruit, the Moraceae Giant. In Sustainable Development and Biodiversity; Springer Nature: Singapore, 2024; pp. 325–355. ISBN 9789819759392. [Google Scholar]
- Karunakaran, G.; Thirugnanavel, A.; Arivalagan, M.; Sankar, C. Artocarpus Heterophyllus, Jackfruit, and Other Artocarpus spp. In Handbooks of Crop Diversity: Conservation and Use of Plant Genetic Resources; Springer Nature: Singapore, 2024; pp. 295–327. ISBN 9789819953479. [Google Scholar]
- Sreehari, S.; Mridul, U.; Adhithya Sankar, S. Biological Extraction of Chitin from Fish Scale Waste Using Proteolytic Bacteria Stenotrophomonas koreensis and Its Possible Application as an Active Packaging Material. Biomass Convers. Biorefin. 2024, 14, 29023–29033. [Google Scholar] [CrossRef]
- Azelee, N.I.W.; Dahiya, D.; Ayothiraman, S.; Noor, N.M.; Rasid, Z.I.A.; Ramli, A.N.M.; Ravindran, B.; Iwuchukwu, F.U.; Selvasembian, R. Sustainable Valorization Approaches on Crustacean Wastes for the Extraction of Chitin, Bioactive Compounds and Their Applications—A Review. Int. J. Biol. Macromol. 2023, 253, 126492. [Google Scholar] [CrossRef] [PubMed]
- Iqbal, N.; Ganguly, P.; Yildizbakan, L.; Raif, E.M.; Jones, E.; Giannoudis, P.V.; Jha, A. Chitosan Scaffolds from Crustacean and Fungal Sources: A Comparative Study for Bone-Tissue-Engineering Applications. Bioengineering 2024, 11, 720. [Google Scholar] [CrossRef] [PubMed]
- Thambiliyagodage, C.; Jayanetti, M.; Mendis, A.; Ekanayake, G.; Liyanaarachchi, H.; Vigneswaran, S. Recent Advances in Chitosan-Based Applications—A Review. Materials 2023, 16, 2073. [Google Scholar] [CrossRef] [PubMed]
- Habibi, A.; Karami, S.; Varmira, K.; Hadadi, M. Key Parameters Optimization of Chitosan Production from Aspergillus terreus Using Apple Waste Extract as Sole Carbon Source. Bioprocess Biosyst. Eng. 2021, 44, 283–295. [Google Scholar] [CrossRef] [PubMed]
- Sen, C.; Ray, P.R.; Hossain, S.; Bhattacharyya, M.; Mondal, S.; Debnath, A. Influence of Nisin on Water Activity, Textural and Other Quality Attributes of Paneer (Indian Cottage Cheese) during Storage. Food Humanit. 2023, 1, 1134–1144. [Google Scholar] [CrossRef]
- Banerjee, K.; van den Bijgaart, H.; Holroyd, S.; Knödlseder, M.; Konings, E. Food Safety Challenges in the Dairy Supply Chain in India: Controlling Risks and Developing a Structured Surveillance System. Int. Dairy J. 2024, 157, 106004. [Google Scholar] [CrossRef]
- Kapoor, R.; Jash, A.; Rizvi, S.S.H. Shelf-Life Extension of Paneer by a Sequential Supercritical-CO2-Based Process. Lebenson. Wiss. Technol. 2021, 135, 110060. [Google Scholar] [CrossRef]
- Sharma, A.; Shivaprasad, D.P.; Chauhan, K.; Taneja, N.K. Control of E. coli Growth and Survival in Indian Soft Cheese (paneer) Using Multiple Hurdles: Phytochemicals, Temperature and Vacuum. Lebenson. Wiss. Technol. 2019, 114, 108350. [Google Scholar] [CrossRef]
- Kumar, A.; Patyal, A. An Insight on Microbial Flora of Milk and Milk Products. In The Microbiology, Pathogenesis and Zoonosis of Milk Borne Diseases; Rana, T., Ed.; Elsevier: Amsterdam, The Netherlands, 2024; pp. 69–94. ISBN 9780443138058. [Google Scholar]
- Torres-León, C.; Aguirre-Joya, J.A.; Aguillón-Gutierrez, D.R. Dryland Microorganisms: Ecology and Biotechnological Potential. In Microbial Biodiversity, Biotechnology and Ecosystem Sustainability; Springer Nature: Singapore, 2023; pp. 1–13. ISBN 9789811943355. [Google Scholar]
- Asghar, W.; Kataoka, R. Fungal Volatiles from Green Manure-Incorporated Soils Promote the Growth of Lettuce (Lactuca sativa) and Mediate Antifungal Activity against Fusarium Oxysporum in vitro. Plant Soil 2025, 507, 77–88. [Google Scholar] [CrossRef]
- da Silva, R.N.A.; Magalhães-Guedes, K.T.; de Oliveira Alves, R.M.; Souza, A.C.; Schwan, R.F.; Umsza-Guez, M.A. Yeast Diversity in Honey and Pollen Samples from Stingless Bees in the State of Bahia, Brazil: Use of the MALDI-TOF MS/genbank Proteomic Technique. Microorganisms 2024, 12, 678. [Google Scholar] [CrossRef] [PubMed]
- Foglia, F.; Greco, G.; Zannella, C.; Chianese, A.; Ambrosino, A.; Conzo, A.; Conzo, G.; De Filippis, A.; Finamore, E.; Docimo, L.; et al. A Case of Magnusiomyces capitatus Isolated during Monitoring in an Antimicrobial Diagnostic Stewardship Context. IDCases 2024, 36, e01959. [Google Scholar] [CrossRef] [PubMed]
- Umesh, M.; Suresh, S.; Santosh, A.S.; Prasad, S.; Chinnathambi, A.; Al Obaid, S.; Jhanani, G.K.; Shanmugam, S. Valorization of Pineapple Peel Waste for Fungal Pigment Production Using Talaromyces albobiverticillius: Insights into Antibacterial, Antioxidant and Textile Dyeing Properties. Environ. Res. 2023, 229, 115973. [Google Scholar] [CrossRef] [PubMed]
- Mao, Z.; Zhang, W.; Wu, C.; Feng, H.; Peng, Y.; Shahid, H.; Cui, Z.; Ding, P.; Shan, T. Diversity and Antibacterial Activity of Fungal Endophytes from Eucalyptus exserta. BMC Microbiol. 2021, 21, 155. [Google Scholar] [CrossRef] [PubMed]
- Umesh, M.; Santhosh, A.S.; Shanmugam, S.; Thazeem, B.; Alharbi, S.A.; Almoallim, H.S.; Chi, N.T.L.; Pugazhendhi, A. Extraction, Characterization, and Fabrication of Cellulose Biopolymer Sheets from Pistia stratiotes as a Biodegradative Coating Material: An Unique Strategy for the Conversion of Invasive Weeds into Value-Added Products. J. Polym. Environ. 2022, 30, 5057–5068. [Google Scholar] [CrossRef]
- Chakraborty, A.; Bhowal, J. Bioconversion of Jackfruit Seed Waste to Fungal Biomass Protein by Submerged Fermentation. Appl. Biochem. Biotechnol. 2023, 195, 2158–2171. [Google Scholar] [CrossRef] [PubMed]
- Koc, B.; Akyuz, L.; Cakmak, Y.S.; Sargin, I.; Salaberria, A.M.; Labidi, J.; Ilk, S.; Cekic, F.O.; Akata, I.; Kaya, M. Production and Characterization of Chitosan-Fungal Extract Films. Food Biosci. 2020, 35, 100545. [Google Scholar] [CrossRef]
- Priyanka, K.; Umesh, M.; Preethi, K. Banana Peels as a Cost Effective Substrate for Fungal Chitosan Synthesis: Optimisation and Characterisation. Environ. Technol. 2023, 1–15. [Google Scholar] [CrossRef] [PubMed]
- Uğurlu, E.; Duysak, Ö. A Study on the Extraction of Chitin and Chitosan from the Invasive Sea Urchin Diadema setosum from Iskenderun Bay in the Northeastern Mediterranean. Environ. Sci. Pollut. Res. Int. 2023, 30, 21416–21424. [Google Scholar] [CrossRef] [PubMed]
- Cai, M.; Wang, Y.; Wang, R.; Li, M.; Zhang, W.; Yu, J.; Hua, R. Antibacterial and Antibiofilm Activities of Chitosan Nanoparticles Loaded with Ocimum basilicum L. Essential Oil. Int. J. Biol. Macromol. 2022, 202, 122–129. [Google Scholar] [CrossRef] [PubMed]
- Elzamly, R.A.; Mohamed, H.M.; Mohamed, M.I.; Zaky, H.T.; Harding, D.R.K.; Kandile, N.G. New Sustainable Chemically Modified Chitosan Derivatives for Different Applications: Synthesis and Characterization. Arab. J. Chem. 2021, 14, 103255. [Google Scholar] [CrossRef]
- Sarier, N.; Eloglu, A.; Onder, E. The Development of Thermoresponsive Multifunctional Chitosan Films Suitable for Food Packaging. Polysaccharides 2025, 6, 17. [Google Scholar] [CrossRef]
- Naik, M.I.; Fomda, B.A.; Jaykumar, E.; Bhat, J.A. Antibacterial Activity of Lemongrass (Cymbopogon citratus) Oil against Some Selected Pathogenic Bacterias. Asian Pac. J. Trop. Med. 2010, 3, 535–538. [Google Scholar] [CrossRef]
- Hisham, F.; Maziati Akmal, M.H.; Ahmad, F.B.; Ahmad, K. Facile Extraction of Chitin and Chitosan from Shrimp Shell. Mater. Today Proc. 2021, 42, 2369–2373. [Google Scholar] [CrossRef]
- Sikorski, D.; Bauer, M.; Frączyk, J.; Draczyński, Z. Antibacterial and Antifungal Properties of Modified Chitosan Nonwovens. Polymers 2022, 14, 1690. [Google Scholar] [CrossRef] [PubMed]
- Liu, Y.; Yuan, Y.; Duan, S.; Li, C.; Hu, B.; Liu, A.; Wu, D.; Cui, H.; Lin, L.; He, J.; et al. Preparation and Characterization of Chitosan Films with Three Kinds of Molecular Weight for Food Packaging. Int. J. Biol. Macromol. 2020, 155, 249–259. [Google Scholar] [CrossRef] [PubMed]
- Aly, M.O.; Ghobashy, S.M.; Aborhyem, S.M. Authentication of Protein, Fat, Carbohydrates, and Total Energy in Commercialized High Protein Sports Foods with Their Labeling Data. Sci. Rep. 2023, 13, 15359. [Google Scholar] [CrossRef] [PubMed]
- Awad, M.F.; El-Shenawy, F.S.; El-Gendy, M.M.A.A.; El-Bondkly, E.A.M. Purification, Characterization, and Anticancer and Antioxidant Activities of L-Glutaminase from Aspergillus versicolor Faesay4. Int. Microbiol. 2021, 24, 169–181. [Google Scholar] [CrossRef] [PubMed]
- Manaswini, S.; Akshata, R.; Bhoomika, V.; Nandini, P.; Ganapathy, K.; Deeshma, K.P. Antimicrobial and Cytotoxic Potential of Endophytic aspergillus Versicolor Isolate from the Medicinal Plant Plectranthus amboinicus. Curr. Microbiol. 2025, 82, 84. [Google Scholar] [CrossRef] [PubMed]
- Kc, C.; Rajeshwari, N. Isolation and Identification of Soil Fungi in Mattavara Forest, Chikamagalur, Karnataka. J. Pharmacogn. Phytochem. 2017, 6, 721–726. [Google Scholar]
- Mukunda, S.; Onkarappa, R.; Prashith, K.T.R. Isolation and Screening of Industrially Important Fungi from the Soils of Western Ghats of Agumbe and Koppa, Karnataka, India. Sci. Technol. Arts Res. 2013, 1, 27. [Google Scholar] [CrossRef]
- Rasmussen, S.; Parsons, A.J.; Bassett, S.; Christensen, M.J.; Hume, D.E.; Johnson, L.J.; Johnson, R.D.; Simpson, W.R.; Stacke, C.; Voisey, C.R.; et al. High Nitrogen Supply and Carbohydrate Content Reduce Fungal Endophyte and Alkaloid Concentration in Lolium perenne. New Phytol. 2007, 173, 787–797. [Google Scholar] [CrossRef] [PubMed]
- Davis, D.; Umesh, M.; Santhosh, A.S.; Suresh, S.; Shanmugam, S.; Kikas, T. Extraction of Fungal Chitosan by Leveraging Pineapple Peel Substrate for Sustainable Biopolymer Production. Polymers 2024, 16, 2455. [Google Scholar] [CrossRef] [PubMed]
- Elgohary, D.M.; El-Sabbagh, S.M.; Mira, H.I.; Desouky, O.A.; Hussien, S.S.; El Naggar, A.M.A.; Ali, A.O.; El-Maadawy, M.M. Chemical Modification of Aspergillus flavus Extracted Chitosan for Uranium Remediation from Aqueous Solution. Int. J. Environ. Anal. Chem. 2024, 1–26. [Google Scholar] [CrossRef]
- Affes, S.; Aranaz, I.; Acosta, N.; Heras, Á.; Nasri, M.; Maalej, H. Chitosan Derivatives-Based Films as pH-Sensitive Drug Delivery Systems with Enhanced Antioxidant and Antibacterial Properties. Int. J. Biol. Macromol. 2021, 182, 730–742. [Google Scholar] [CrossRef] [PubMed]
- Lam, I.L.J.; Mohd Affandy, M.A.; ’Aqilah, N.M.N.; Vonnie, J.M.; Felicia, W.X.L.; Rovina, K. Physicochemical Characterization and Antimicrobial Analysis of Vegetal Chitosan Extracted from Distinct Forest Fungi Species. Polymers 2023, 15, 2328. [Google Scholar] [CrossRef] [PubMed]
- Leo Edward, M.; Dharanibalaji, K.C.; Kumar, K.T.; Chandrabose, A.R.S.; Shanmugharaj, A.M.; Jaisankar, V. Preparation and Characterisation of Chitosan Extracted from Shrimp Shell (Penaeus monodon) and Chitosan-Based Blended Solid Polymer Electrolyte for Lithium-Ion Batteries. Polym. Bull. 2022, 79, 587–604. [Google Scholar] [CrossRef]
- Padmakumari, R.; Ravindrachary, V.; Mahantesha, B.K.; Sagar, R.N.; Sahanakumari, R.; Bhajantri, R.F. Modification of Fluorescence and Optical Properties of Rhodamine B Dye Doped PVA/Chitosan Polymer Blend Films. AIP Conf. Proc. 2018, 1953, 030248. [Google Scholar] [CrossRef]
- Kuyyogsuy, A. Preparation and Characterization of Chitosan Obtained from Pacific White Shrimp Shells and Its in Vitro Antifungal Activity. Asian J. Chem. 2020, 32, 2515–2519. [Google Scholar] [CrossRef]
- Rostami, N.; Dekamin, M.G.; Valiey, E.; Fanimoghadam, H. Chitosan-EDTA-Cellulose Network as a Green, Recyclable and Multifunctional Biopolymeric Organocatalyst for the One-Pot Synthesis of 2-Amino-4H-Pyran Derivatives. Sci. Rep. 2022, 12, 8642. [Google Scholar] [CrossRef] [PubMed]
- Qiao, C.; Ma, X.; Wang, X.; Liu, L. Structure and Properties of Chitosan Films: Effect of the Type of Solvent Acid. LWT 2021, 135, 109984. [Google Scholar] [CrossRef]
- Cai, Z.; Chen, P.; Jin, H.-J.; Kim, J. The Effect of Chitosan Content on the Crystallinity, Thermal Stability, and Mechanical Properties of Bacterial Cellulose—Chitosan Composites. Proc. Inst. Mech. Eng. Part C 2009, 223, 2225–2230. [Google Scholar] [CrossRef]
- Piekarska, K.; Sikora, M.; Owczarek, M.; Jóźwik-Pruska, J.; Wiśniewska-Wrona, M. Chitin and Chitosan as Polymers of the Future-Obtaining, Modification, Life Cycle Assessment and Main Directions of Application. Polymers 2023, 15, 793. [Google Scholar] [CrossRef] [PubMed]
- Ssekatawa, K.; Byarugaba, D.K.; Wampande, E.M.; Moja, T.N.; Nxumalo, E.; Maaza, M.; Sackey, J.; Ejobi, F.; Kirabira, J.B. Isolation and Characterization of Chitosan from Ugandan Edible Mushrooms, Nile Perch Scales and Banana Weevils for Biomedical Applications. Sci. Rep. 2021, 11, 4116. [Google Scholar] [CrossRef] [PubMed]
- Kaya, M.; Akata, I.; Baran, T.; Menteş, A. Physicochemical Properties of Chitin and Chitosan Produced from Medicinal Fungus (Fomitopsis pinicola). Food Biophys. 2015, 10, 162–168. [Google Scholar] [CrossRef]
- Bashir, T.; Dutta, J.; Masarat, S.; Kyzas, G.Z. Formulation and Characterization of Lignin Modified Chitosan Beads. Adsorption 2024, 30, 947–955. [Google Scholar] [CrossRef]
- Öğretmen, Ö.Y.; Karsli, B.; Çağlak, E. Extraction and Physicochemical Characterization of Chitosan from Pink Shrimp (Parapenaeus longirostris) Shell Wastes. J. Agric. Sci. 2022, 28, 490–500. [Google Scholar] [CrossRef]
- Saravanan, V.; Davoodbasha, M.; Rajesh, A.; Nooruddin, T.; Lee, S.-Y.; Kim, J.-W. Extraction and Characterization of Chitosan from Shell of Borassus flabellifer and Their Antibacterial and Antioxidant Applications. Int. J. Biol. Macromol. 2023, 253, 126592. [Google Scholar] [CrossRef] [PubMed]
- Masilompane, T.M.; Chaukura, N.; Mishra, S.B.; Mishra, A.K. Chitosan-Lignin-Titania Nanocomposites for the Removal of Brilliant Black Dye from Aqueous Solution. Int. J. Biol. Macromol. 2018, 120, 1659–1666. [Google Scholar] [CrossRef] [PubMed]
- Jantzen da Silva Lucas, A.; Quadro Oreste, E.; Leão Gouveia Costa, H.; Martín López, H.; Dias Medeiros Saad, C.; Prentice, C. Extraction, Physicochemical Characterization, and Morphological Properties of Chitin and Chitosan from Cuticles of Edible Insects. Food Chem. 2021, 343, 128550. [Google Scholar] [CrossRef] [PubMed]
- Kamaludin, N.H.I.; Ismail, H.; Rusli, A.; Ting, S.S. Thermal Behavior and Water Absorption Kinetics of Polylactic Acid/chitosan Biocomposites. Iran. Polym. J. 2021, 30, 135–147. [Google Scholar] [CrossRef]
- Soon, C.Y.; Tee, Y.B.; Tan, C.H.; Rosnita, A.T.; Khalina, A. Extraction and Physicochemical Characterization of Chitin and Chitosan from Zophobas morio Larvae in Varying Sodium Hydroxide Concentration. Int. J. Biol. Macromol. 2018, 108, 135–142. [Google Scholar] [CrossRef] [PubMed]
- Zhang, W.; Jiang, W. Antioxidant and Antibacterial Chitosan Film with Tea Polyphenols-Mediated Green Synthesis Silver Nanoparticle via a Novel One-Pot Method. Int. J. Biol. Macromol. 2020, 155, 1252–1261. [Google Scholar] [CrossRef] [PubMed]
- Kanthiya, T.; Kiattipornpithak, K.; Thajai, N.; Phimolsiripol, Y.; Rachtanapun, P.; Thanakkasaranee, S.; Leksawasdi, N.; Tanadchangsaeng, N.; Sawangrat, C.; Wattanachai, P.; et al. Modified Poly(lactic Acid) Epoxy Resin Using Chitosan for Reactive Blending with Epoxidized Natural Rubber: Analysis of Annealing Time. Polymers 2022, 14, 1085. [Google Scholar] [CrossRef] [PubMed]
- Prashanth, K.P.; Sanman, S.; Lokesh, G.N. A Study on Tensile and Tear Properties for Chitosan Blended with and without Natural Fiber Films. In Lecture Notes in Mechanical Engineering; Springer: Singapore, 2021; pp. 61–73. ISBN 9789811620850. [Google Scholar]
- Ke, C.-L.; Deng, F.-S.; Chuang, C.-Y.; Lin, C.-H. Antimicrobial Actions and Applications of Chitosan. Polymers 2021, 13, 904. [Google Scholar] [CrossRef] [PubMed]
- Perdana, M.I.; Ruamcharoen, J.; Panphon, S.; Leelakriangsak, M. Antimicrobial Activity and Physical Properties of Starch/chitosan Film Incorporated with Lemongrass Essential Oil and Its Application. Lebenson. Wiss. Technol. 2021, 141, 110934. [Google Scholar] [CrossRef]
- Shendurse, A.M.; Sangwan, R.B.; Amit, K.; Ramesh, V.; Patel, A.C.; Gopikrishna, G.; Roy, S.K. Phytochemical Screening and Antibacterial Activity of Lemongrass (Cymbopogon citratus) Leaves Essential Oil. J. Pharmacogn. Phytochem. 2021, 10, 445–449. [Google Scholar]
- Silva, R.R.A.; Marques, C.S.; Arruda, T.R.; Teixeira, S.C.; de Oliveira, T.V. Biodegradation of Polymers: Stages, Measurement, Standards and Prospects. Macromol 2023, 3, 371–399. [Google Scholar] [CrossRef]
- Nasrollahzadeh, M. Biopolymer-Based Metal Nanoparticle Chemistry for Sustainable Applications: Volume 1: Classification, Properties and Synthesis; Elsevier Science Publishing: Philadelphia, PA, USA, 2021; ISBN 9780128221082. [Google Scholar]
- Bher, A.; Mayekar, P.C.; Auras, R.A.; Schvezov, C.E. Biodegradation of Biodegradable Polymers in Mesophilic Aerobic Environments. Int. J. Mol. Sci. 2022, 23, 12165. [Google Scholar] [CrossRef] [PubMed]
- Bacha, A.-U.-R.; Nabi, I.; Zaheer, M.; Jin, W.; Yang, L. Biodegradation of Macro- and Micro-Plastics in Environment: A Review on Mechanism, Toxicity, and Future Perspectives. Sci. Total Environ. 2023, 858, 160108. [Google Scholar] [CrossRef] [PubMed]
- Pavoni, J.M.F.; dos Santos, N.Z.; May, I.C.; Pollo, L.D.; Tessaro, I.C. Impact of Acid Type and Glutaraldehyde Crosslinking in the Physicochemical and Mechanical Properties and Biodegradability of Chitosan Films. Polym. Bull. 2021, 78, 981–1000. [Google Scholar] [CrossRef]
- Hasan, M.; Gopakumar, D.A.; Olaiya, N.G.; Zarlaida, F.; Alfian, A.; Aprinasari, C.; Alfatah, T.; Rizal, S.; Khalil, H.P.S.A. Evaluation of the Thermomechanical Properties and Biodegradation of Brown Rice Starch-Based Chitosan Biodegradable Composite Films. Int. J. Biol. Macromol. 2020, 156, 896–905. [Google Scholar] [CrossRef] [PubMed]
- Suresh, P.V.; Raj, K.R.; Nidheesh, T.; Pal, G.K.; Sakhare, P.Z. Application of Chitosan for Improvement of Quality and Shelf Life of Table Eggs under Tropical Room Conditions. J. Food Sci. Technol. 2015, 52, 6345–6354. [Google Scholar] [CrossRef] [PubMed]
- Kanatt, S.R.; Rao, M.S.; Chawla, S.P.; Sharma, A. Effects of Chitosan Coating on Shelf-Life of Ready-to-Cook Meat Products during Chilled Storage. Lebenson. Wiss. Technol. 2013, 53, 321–326. [Google Scholar] [CrossRef]

| Biochemical Composition | Average |
|---|---|
| Moisture content (w/w%) | 82.61 ± 0.030% |
| Ash content (w/w%) | 2.11 ± 0.007% |
| Carbohydrate (w/w%) | 17.07 ± 0.017% |
| Protein (w/w%) | 11.40 ± 0.027% |
| Parameters | Day 0 | Day 14 | |
|---|---|---|---|
| Unwrapped | Wrapped | ||
| Protein (w/w%) | 23.37 | 21.87 | 21.12 |
| Fat (w/w%) | 19.61 | 18.11 | 18.27 |
| Carbohydrate (w/w%) | 11.23 | 8.5 | 11.13 |
Disclaimer/Publisher’s Note: The statements, opinions and data contained in all publications are solely those of the individual author(s) and contributor(s) and not of MDPI and/or the editor(s). MDPI and/or the editor(s) disclaim responsibility for any injury to people or property resulting from any ideas, methods, instructions or products referred to in the content. |
© 2025 by the authors. Licensee MDPI, Basel, Switzerland. This article is an open access article distributed under the terms and conditions of the Creative Commons Attribution (CC BY) license (https://creativecommons.org/licenses/by/4.0/).
Share and Cite
Santhosh, A.S.; Umesh, M. Harnessing Wild Jackfruit Extract for Chitosan Production by Aspergillus versicolor AD07: Application in Antibacterial Biodegradable Sheets. Appl. Microbiol. 2025, 5, 71. https://doi.org/10.3390/applmicrobiol5030071
Santhosh AS, Umesh M. Harnessing Wild Jackfruit Extract for Chitosan Production by Aspergillus versicolor AD07: Application in Antibacterial Biodegradable Sheets. Applied Microbiology. 2025; 5(3):71. https://doi.org/10.3390/applmicrobiol5030071
Chicago/Turabian StyleSanthosh, Adhithya Sankar, and Mridul Umesh. 2025. "Harnessing Wild Jackfruit Extract for Chitosan Production by Aspergillus versicolor AD07: Application in Antibacterial Biodegradable Sheets" Applied Microbiology 5, no. 3: 71. https://doi.org/10.3390/applmicrobiol5030071
APA StyleSanthosh, A. S., & Umesh, M. (2025). Harnessing Wild Jackfruit Extract for Chitosan Production by Aspergillus versicolor AD07: Application in Antibacterial Biodegradable Sheets. Applied Microbiology, 5(3), 71. https://doi.org/10.3390/applmicrobiol5030071






